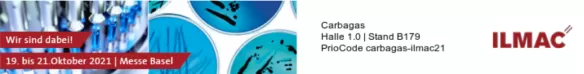
Carbagas Tickets ILMAC

Lernen Sie unsere Experten für Labor- und Pharmalösungen kennen, die Ihnen unsere speziell auf Ihre Bedürfnisse abgestimmten Gase und Geräte vorstellen. Unter anderem den Kryobehälter mit der aussergewöhnlichen Präsenz von Vertretern der Air Liquide-Tochtergesellschaft Cryopal, die auf Kryogeräte für den Pharma-, Labor- und Medizinbereich spezialisiert ist. Sowie unsere neue Lösung: spezifische Wasseraufbereitung, die aus der Partnerschaft zwischen Air Liquide und Inopsys hervorgegangen ist, einem Unternehmen, das auf die Aufbereitung und Aufwertung von Abwasser aus der pharmazeutischen und chemischen Industrie spezialisiert ist.
Noch mehr zu entdecken:
- Unsere Laborgeräte: SGA Kompakt-Umschaltstation, Reinstgasregler
- Unsere Pharma-Gasanlagen: CISA-Umschalt-/Expansionsstation, Modul für Netzanschluss
- Unsere E-data-App, mit der Sie mit nur einem Klick die Analysenzertifikate und Sicherheitsdatenblätter für Ihre Gasgemische erhalten
Wir freuen uns, Sie vom 19.- 21. Oktober an unserem Stand B179 in Halle 1 an der Messe Basel begrüssen zu dürfen.